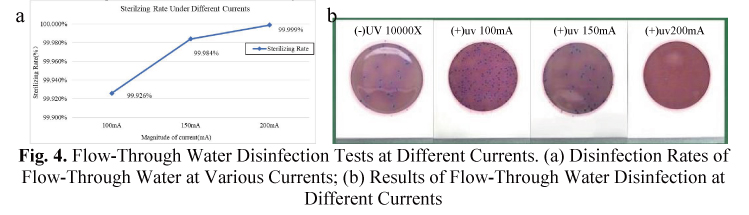
1-04

Abstract
This study systematically investigates the performance optimization of UV-C LED water disinfection modules, focusing on the effects of heat dissipation materials, driving current, and optical structure design on sterilization efficiency. The results demonstrate that copper substrates significantly reduce the light power attenuation rate of UV-C LEDs compared to aluminum substrates (41.90% vs. 53.94%), thereby extending the operational lifespan of the device. In flow-through water disinfection experiments, increasing the driving current (from 100 mA to 200 mA) markedly enhances inactivation efficiency, achieving an Escherichia coli inactivation rate of >99.999% at 200 mA, which meets drinking water disinfection standards. Furthermore, by optimizing the optical design, the number of UV-C LED beads was reduced from six to four, and individual perforations for each bead were employed to enhance ultraviolet reflection. This approach maintained a high sterilization rate of 99.999% while reducing costs by 33%. This study provides critical theoretical foundations and engineering references for the design of efficient, cost-effective, and long-lasting UV-C LED water disinfection systems.
Keywords: Water Disinfection, UV-C LED, Escherichia coli, Sterilization Rate, Mercury-Free, UV-C LED, Water Disinfection.
1. Introduction
Water safety is a critical global health concern, as consumption of water contaminated with pathogenic bacteria, protozoa, and viruses can lead to waterborne diseases in humans and animals, including gastroenteritis, myocarditis, encephalitis, typhoid fever, rotavirus diarrhea, and epidemic cholera, some of which are leading causes of human mortality [1-3]. Effective disinfection strategies for inactivating waterborne viruses are essential in water treatment processes, as they ensure the elimination of pathogenic microorganisms responsible for waterborne diseases. Common disinfection methods and techniques for viral inactivation in water include traditional chemical treatments such as chlorination, as well as physical disinfection methods like membrane filtration and ultraviolet (UV) irradiation [4].
In the field of drinking water disinfection, traditional chemical disinfection methods, such as chlorine, monochloramine, and chlorine dioxide, are widely employed [5]. Chlorine induces mutations in microbial DNA by altering purine and pyrimidine sequences, disrupting protein synthesis and glucose transport, thereby inhibiting microbial reproduction [6]. However, a significant drawback is that chlorine reacts with organic matter in water to form disinfection byproducts, such as trihalomethanes, which pose potential carcinogenic and teratogenic risks to human health [7].
Membrane filtration is an efficient technique that removes suspended particles, bacteria, and organic matter from drinking water and wastewater by passing water through a physical barrier. However, its disinfection efficacy is influenced by water quality, the content of solid particles, and fouling during the treatment process. Moreover, membrane permeability decreases with increased biofouling, reducing its ability to retain viruses [8].
UV irradiation, as a physical disinfection method, has garnered significant attention in microbial inactivation due to its notable advantages, including the absence of chemical additives and the lack of disinfection byproducts [9]. However, traditional mercury-based UV disinfection technology has several limitations, including: 1) the risk of mercury contamination; 2) short lamp lifespan (typically 5,000–9,000 hours); 3) long warm-up times (3–5 minutes); 4) low energy conversion efficiency (approximately 30–40%); and 5) bulky size with limited high-frequency switching capability. In contrast, UV-C light-emitting diode (LED) technology based on GaN materials offers significant advantages: 1) mercury-free and environmentally friendly; 2) ultra-long lifespan (exceeding 20,000 hours); 3) instant on/off functionality (response time <1 μs); 4) tunable wavelength (260–280 nm); 5) compact size (chip size <1 mm²); and 6) support for high-frequency pulsed operation [10-13]. These characteristics position UV-C LEDs as an ideal choice for next-generation water disinfection technologies.
In recent years, significant progress has been made in the application of UV-C LED technology for microbial inactivation. Building on prior research, this study systematically optimizes the performance parameters of UV-C LED water disinfection modules, with a focus on investigating the mechanisms by which heat dissipation material properties, driving current intensity, and optical structure design influence sterilization efficiency. These findings provide critical technical support for the development of novel, high-efficiency UV-C LED water treatment systems, with broad applications in drinking water purification, domestic water disinfection, and industrial water supply treatment, offering significant social benefits and practical value.
2 Material and method
2.1 MASSPHOTON UV-C LED Bead
This study employs high-power 270–280 nm gallium nitride (GaN)-based UV-C LED chips, achieving high-quality bonding between the chip and ceramic substrate through an optimized eutectic soldering process. Experimental results demonstrate that this encapsulation technique significantly reduces the interface void ratio, lowering the thermal resistance to 8.2 K/W, which represents an approximately 40% improvement in heat dissipation efficiency compared to conventional silver adhesive bonding methods. The encapsulation structure utilizes high-transmittance JGS1 quartz glass as the light output window, with spectrophotometer tests indicating a transmittance of over 90% at the 270 nm wavelength. Accelerated aging tests (85°C/85% RH) reveal that the encapsulated device maintains approximately 90% of its initial optical power after 1000 hours of continuous operation, significantly enhancing the reliability and lifespan of UV-C LED devices. This optimized encapsulation approach provides robust technical support for the application of deep-ultraviolet LEDs in sterilization and disinfection fields.
Fig.1. MASSPHOTON UV-C packaged LED
2.2 Microbial Samples
The test strain used was Escherichia coli (8099). The second-generation E. coli (8099) was procured, streaked onto agar plates for activation, and then used to prepare a bacterial suspension. Fresh E. coli slant cultures from the third to seventh generations, incubated at 36 ± 1°C for 18–24 hours, were inoculated into LB liquid medium and cultured in a constant-temperature incubator at 36 ± 0.5°C for 16–20 hours. After significant bacterial proliferation, the cultures were stored at room temperature for subsequent use.
2.3 Detection Method
The experimental procedure followed Appendix E of GB28235-2020, Hygienic Requirements for Ultraviolet Appliance of Disinfection, specifically the laboratory microbial inactivation test method for water disinfection. For disinfectors used in drinking water treatment, the test water sample was contaminated with a prepared Escherichia coli suspension added to dechlorinated tap water or distilled water, achieving a bacterial concentration of 5×10⁴ CFU/100 mL to 5×10⁵ CFU/100 mL. The water samples were divided into a blank control group (untreated) and an experimental group (water samples collected after passing through the UV-C LED water disinfection module at a set flow rate, e.g., 4 L/min or 9 L/min). The total bacterial colony counts in both groups were determined using the standard plate counting method, and the logarithmic inactivation (log inactivation) was calculated.
3. Result and discussions
3.1 Correlation Between Irradiation Intensity and Water Module Materials
The MASSPHOTON water disinfection module (Figure 2) employs mercury-free UV-C LED disinfection technology, fundamentally eliminating the risk of heavy metal contamination associated with traditional mercury lamps. The module is encased in 316L medical-grade stainless steel, which prevents the release of harmful metal ions during prolonged water contact. The module features a fully enclosed optical design, with all ultraviolet light sources sealed within the casing, ensuring no risk of radiation exposure during operation. The inlet and outlet are sealed with food-grade silicone plugs, which have passed water pressure tests ranging from 0.35 to 0.7 MPa and long-term operational tests at a flow rate of 4 L/min without any leakage, demonstrating excellent mechanical sealing performance. This design ensures high sterilization efficiency while fully meeting the safety and reliability requirements for drinking water treatment equipment.
Fig.2. Physical Diagram of the MASSPHOTON Water Disinfection Module
The optimal operating efficiency range for UV-C LED beads is 25°C–60°C. Exceeding this temperature range may lead to light power attenuation or wavelength shift, making effective thermal management critical for ensuring the sterilization performance of water disinfection modules. Metal materials, due to their excellent thermal conductivity, can effectively reduce the operating temperature of LED beads. To compare the thermal dissipation performance of different metal substrates, this study selected copper and aluminum substrates as the base materials for UV-C LED beads and tested their temperature variations over 30 minutes of continuous operation under both static (no water flow) and dynamic (water flow) conditions.
Experimental results indicate that, under both static and dynamic conditions, the operating temperatures of UV-C LEDs with copper and aluminum substrates were similar, showing no significant differences (Figure 3a). However, in a 30-minute aging test, the UV-C LED with a copper substrate exhibited an initial irradiance of 420 µW/cm², which decreased to 244 µW/cm², resulting in a light power (PD value) attenuation rate of 41.90%. In contrast, the UV-C LED with an aluminum substrate had an initial irradiance of 350 µW/cm², which dropped to 161 µW/cm², with a PD attenuation rate of 53.94% (Figure 3b).
These findings suggest that, while the short-term thermal dissipation performance of the two metal substrates is comparable, copper substrates more effectively mitigate the long-term light power attenuation of UV-C LEDs, thereby extending the operational lifespan of water disinfection modules. These results provide significant guidance for the thermal design of UV-C LED water treatment systems, recommending the preferential use of copper substrates as heat dissipation materials in high-power, long-duration applications.
Fig. 3. Temperature and Aging Tests of UV-C LED Strip Substrates with Two Different Materials. a. Temperature Variations of the Two Materials under Static (No Water) and Flowing Water Conditions; b. Comparison of Ultraviolet Irradiance Attenuation for the Two Materials as Substrates.
3.2 Study on the Sterilization Efficacy of UV-C LED under Different Driving Currents
For flow-through water disinfection scenarios, the inactivation efficacy of UV-C LEDs against Escherichia coli (ATCC 8099) was investigated under varying driving currents. Based on prior studies, achieving a 5-log (99.999%) inactivation within a 1-second contact time requires an ultraviolet radiation dose of 40–60 mJ/cm². The experiment utilized an array of six UV-C LED beads produced by MASSPHOTON, tested at driving currents of 100 mA, 150 mA, and 200 mA. The results (Figure 4a) demonstrate a significant positive correlation between bacterial inactivation efficiency and driving current: at 100 mA, an inactivation efficiency of 99.926% was achieved; at 150 mA, the efficiency increased to 99.984%; and at 200 mA, the system consistently achieved an inactivation efficiency exceeding 5-log (99.999%), fully meeting the stringent requirements for drinking water disinfection.
These findings confirm that optimizing the driving current can effectively enhance the sterilization performance of UV-C LED systems. At a working current of 200 mA, the system met industry-standard disinfection requirements (NSF/ANSI 55), providing critical experimental evidence for the engineering parameter design of UV-C LED flow-through water disinfection systems.
Fig. 4. Flow-Through Water Disinfection Tests at Different Currents. (a) Disinfection Rates of Flow-Through Water at Various Currents; (b) Results of Flow-Through Water Disinfection at Different Currents
3.3 Study on the Impact of UV-C LED Bead Quantity and High-Transmittance Materials on Sterilization Efficiency
This study achieved the goal of enhancing sterilization efficiency while reducing costs through the optimization of UV-C LED bead arrangement and optical structure design. Specific improvements include: 1) reducing the number of UV-C LED beads from six to four, significantly lowering production costs; 2) innovatively modifying the combination of high-transmittance materials by transitioning from a conventional single-opening design for the entire light strip to an independent opening design for individual LED beads. Sterilization performance test data (Table 1) demonstrate that the optimized structure, despite a 33% reduction in LED bead quantity, maintains a high inactivation rate of 99.9999% against Escherichia coli in flowing water at 4 L/min. These findings provide valuable reference for the cost-effective and high-efficiency design of UV-C sterilization equipment.
Table 1. Sterilization Test Results for Different Numbers of UV-C LED Beads
IV. CONCLUSION
This study systematically evaluated the key performance parameters of UV-C LED water disinfection modules, including the selection of heat dissipation materials, optimization of driving current, and design of LED bead arrangement and optical structure, providing critical insights for the development of efficient and cost-effective UV-C LED sterilization systems. Experimental results indicate that copper and aluminum substrates exhibit comparable short-term heat dissipation performance; however, copper substrates demonstrate superior long-term stability, with a significantly lower light power attenuation rate (41.90%) compared to aluminum substrates (53.94%). This suggests that copper substrates are more effective in maintaining stable UV-C output in high-power, long-term water disinfection systems, thereby extending the operational lifespan of the equipment. The investigation into the impact of driving current on sterilization efficiency revealed that increasing the current significantly enhances the disinfection performance of UV-C LEDs. At a driving current of 200 mA, the system consistently achieved an Escherichia coli inactivation rate of 99.9999%, fully complying with drinking water disinfection standards (NSF/ANSI 55). By reducing the number of UV-C LED beads from six to four and optimizing the optical design (incorporating individual perforations for each bead and enhanced reflective structures), a high sterilization rate of 99.9999% was maintained while reducing hardware costs by 33%. This optimization not only improved light energy utilization efficiency but also lowered production costs, offering a viable solution for the commercial adoption of UV-C LED disinfection systems.
In summary, this study achieved comprehensive improvements in the performance, cost-effectiveness, and reliability of UV-C LED water disinfection modules through material optimization, electrical parameter adjustments, and structural innovations. Future research could further explore the long-term stability of higher-power UV-C LEDs and the impact of varying water quality conditions (e.g., turbidity and organic content) on sterilization efficiency to promote the application of this technology in a broader range of scenarios.
REFERENCES
1. Griffiths, J.K., Waterborne Diseases. International Encyclopedia of Public Health (Second Edition), 2017: p. Pages 388-401.
2. Lanrewaju AA, E.A.S.S., A review on disinfection methods for inactivation of waterborne viruses. Front Microbiol, 2022(13:991856. doi: 10.3389/fmicb.2022.991856. PMID: 36212890; PMCID: PMC9539188.).
3. Lanrewaju AA, E.A.S.S., Global public health implications of human exposure to viral contaminated water. Front Microbiol, 2022(13:981896. doi: 10.3389/fmicb.2022.981896. PMID: 36110296; PMCID: PMC9468673.).
4. Collivignarelli M. C., A.A.B.I., Overview of the main disinfection processes for wastewater and drinking water treatment plants. Sustainability, 2018(10:86.).
5. Xiao, R., Y. Duan and W. Chu, The effectiveness of household water treatment and safe storage in improving drinking water quality: a disinfection by-product (DBP) perspective. Journal of water supply: Research and technology, 2020. 69(7/8): p. 785-806.
6. Kumar S., G.A.K.M., Chemical treatment for removal of waterborne pathogens. Waterborne Pathog, 2020(205–218. doi: 10.1016/B978-0-12-818783-8.00011-6).
7. Gall A. M., S.J.L.M., Inactivation kinetics and replication cycle inhibition of adenovirus by monochloramine. Environ. Sci. Technol. Lett., 2016.3, 185–189.
8. Chen C., G.L.Y.Y., Comparative effectiveness of membrane technologies and disinfection methods for virus elimination in water: a review. Sci. Total Environ., 2021(801:149678. doi: 10.1016/j.scitotenv.2021.149678).
9. Oguma K., R.S., UV inactivation of viruses in water: its potential to mitigate current and future threats of viral infectious diseases. Jpn. J. Appl. Phys., 2021(60:110502).
10. Nyangaresi PO, Q.Y.C.G., Comparison of the performance of pulsed and continuous UVC-LED irradiation in the inactivation of bacteria. Water Res., 2019.157:218-227.
11. Pelayo D, H.A.S.G., Performance of high-efficiency UV-C LEDs in water disinfection: Experimental, life cycle assessment, and economic analysis of different operational scenarios. J Environ Manage., 2024.364:121442.
12. Würtele MA, K.T.L.M., Application of GaN-based ultraviolet-C light emitting diodes--UV LEDs--for water disinfection. Water Res., 2011(45(3):1481-9.
13. Mohaghegh Montazeri M, H.S.T.F., Ultraviolet light-emitting diode (UV-LED) water disinfection photoreactors: A review. J Environ Manage, 2025(386:125678. doi: 10.1016/j.jenvman.2025.125678. Epub 2025 May 14. PMID: 40373433.
1. Griffiths, J.K., Waterborne Diseases. International Encyclopedia of Public Health (Second Edition), 2017: p. Pages 388-401.
2. Lanrewaju AA, E.A.S.S., A review on disinfection methods for inactivation of waterborne viruses. Front Microbiol, 2022(13:991856. doi: 10.3389/fmicb.2022.991856. PMID: 36212890; PMCID: PMC9539188.).
3. Lanrewaju AA, E.A.S.S., Global public health implications of human exposure to viral contaminated water. Front Microbiol, 2022(13:981896. doi: 10.3389/fmicb.2022.981896. PMID: 36110296; PMCID: PMC9468673.).
4. Collivignarelli M. C., A.A.B.I., Overview of the main disinfection processes for wastewater and drinking water treatment plants. Sustainability, 2018(10:86.).
5. Xiao, R., Y. Duan and W. Chu, The effectiveness of household water treatment and safe storage in improving drinking water quality: a disinfection by-product (DBP) perspective. Journal of water supply: Research and technology, 2020. 69(7/8): p. 785-806.
6. Kumar S., G.A.K.M., Chemical treatment for removal of waterborne pathogens. Waterborne Pathog, 2020(205–218. doi: 10.1016/B978-0-12-818783-8.00011-6).
7. Gall A. M., S.J.L.M., Inactivation kinetics and replication cycle inhibition of adenovirus by monochloramine. Environ. Sci. Technol. Lett., 2016.3, 185–189.
8. Chen C., G.L.Y.Y., Comparative effectiveness of membrane technologies and disinfection methods for virus elimination in water: a review. Sci. Total Environ., 2021(801:149678. doi: 10.1016/j.scitotenv.2021.149678).
9. Oguma K., R.S., UV inactivation of viruses in water: its potential to mitigate current and future threats of viral infectious diseases. Jpn. J. Appl. Phys., 2021(60:110502).
10. Nyangaresi PO, Q.Y.C.G., Comparison of the performance of pulsed and continuous UVC-LED irradiation in the inactivation of bacteria. Water Res., 2019.157:218-227.
11. Pelayo D, H.A.S.G., Performance of high-efficiency UV-C LEDs in water disinfection: Experimental, life cycle assessment, and economic analysis of different operational scenarios. J Environ Manage., 2024.364:121442.
12. Würtele MA, K.T.L.M., Application of GaN-based ultraviolet-C light emitting diodes--UV LEDs--for water disinfection. Water Res., 2011(45(3):1481-9.
13. Mohaghegh Montazeri M, H.S.T.F., Ultraviolet light-emitting diode (UV-LED) water disinfection photoreactors: A review. J Environ Manage, 2025(386:125678. doi: 10.1016/j.jenvman.2025.125678. Epub 2025 May 14. PMID: 40373433.

MASSPHOTON will participate in WATERTECH CHINA 2026 (June 9–11, Shanghai), showcasing advanced UVC LED water disinfection modules for residential, commercial, and industrial applications. With 5-log (99.999%) disinfection performance, mercury-free operation, and high integration flexibility, the solutions support sustainable and smart water treatment. Visitors are invited to explore innovations at Booth 2.1H-413.
MASSPHOTON will participate in WATERTECH CHINA 2026 (June 9–11, Shanghai), showcasing advanced UVC LED water disinfection modules for residential, commercial, and industrial applications. With 5-log (99.999%) disinfection performance, mercury-free operation, and high integration flexibility, the solutions support sustainable and smart water treatment. Visitors are invited to explore innovations at Booth 2.1H-413. This study examines how temperature influences UV-C LED performance and water disinfection efficiency. Higher temperatures reduce output power, accelerate degradation, and lead to insufficient disinfection dose. Effective thermal management is essential to ensure stable performance and reliable sterilization.
This study examines how temperature influences UV-C LED performance and water disinfection efficiency. Higher temperatures reduce output power, accelerate degradation, and lead to insufficient disinfection dose. Effective thermal management is essential to ensure stable performance and reliable sterilization.







